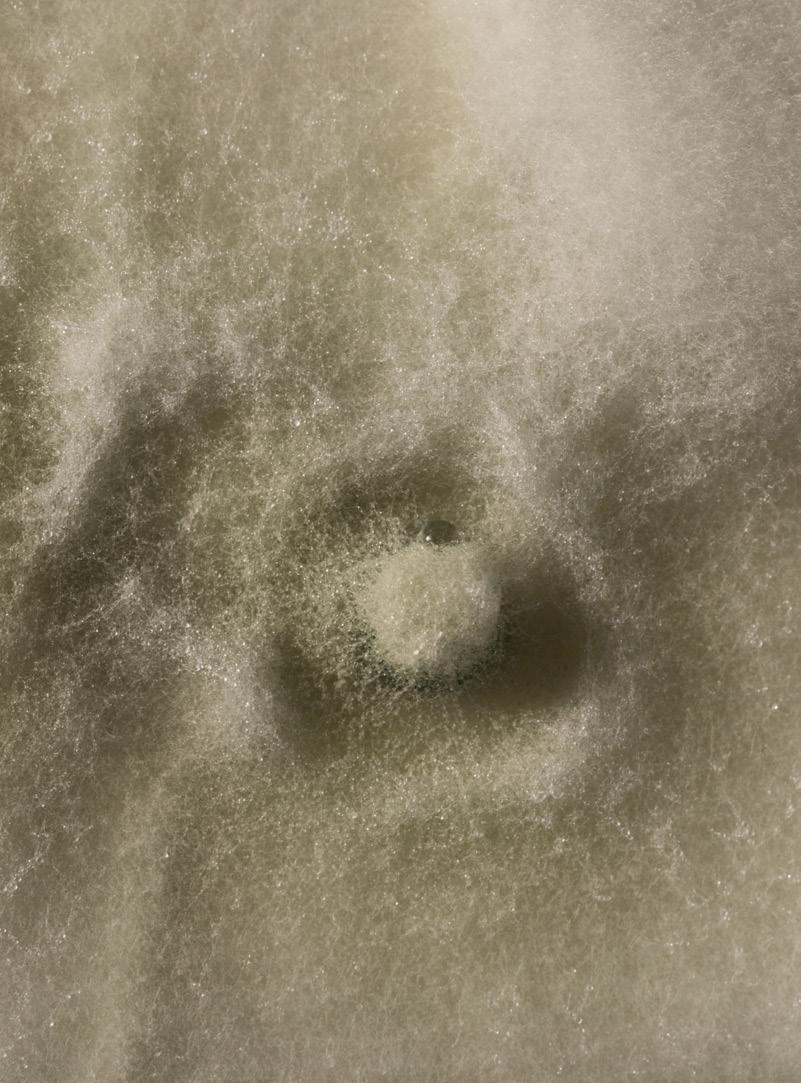

André Martins
Gerente General de Koppert Andina

Desde principios de este año, Koppert Brasil ha pasado por una fase de expansión, asumiendo el liderazgo de Koppert Andina, que abarca Chile, Colombia, Perú y Ecuador. En esta entrevista exclusiva, tuvimos el privilegio de conversar con André Martins, Gerente General de Koppert Andina, para explorar los detalles de esta significativa transición y comprender mejor los impactos y oportunidades que surgen con este nuevo liderazgo.
BioJournal: ¿Cuál es la estrategia de Koppert para expandir el uso de productos biológicos entre los productores y aumentar la producción y la productividad?
André Martins: Perú se destaca por su fruticultura, siendo el mayor productor de arándanos y uno de los principales exportadores de frutas, lo que lo convierte en nuestro mercado foco. Además, hay una presencia significativa de caña de azúcar, aunque en menor escala que en Brasil. En Chile, también encontramos una fuerte presencia en la fruticultura, la horticultura y el cultivo del tomate. En Colombia, nos dedicamos a la producción de rosas y flores ornamentales, con planes futuros para la expansión de cultivos como el café, aguacate y otras frutas. En Ecuador, predominan cultivos como la banana orgánica, el cacao y la caña
de azúcar representando un mercado en alza. Además, el mercado de semillas, con producción en Chile y Perú, se presentan como una gran oportunidad para Koppert.
Hablando del equipo, ¿Cómo está siendo el proceso de expansión? En la actualidad, estamos utilizando el equipo existente, mientras llevamos a cabo una reestructuración laboral. Nuestro objetivo es empezar a aumentar el número de colaboradores a partir de 2025, como parte de un cambio en nuestro enfoque operativo. Estamos enfocados, no solo en el fortalecimiento de nuestro equipo de ventas y desarrollo del mercado, sino también, en mejorar nuestra estrategia de distribución, con el objetivo de llegar a un número aún mayor de productores.
4
¿Cuál es la expectativa de Koppert Global con respecto al liderazgo de Brasil?
Con la proximidad logística de la que ahora disfrutamos, tenemos previsto introducir algunos de los productos brasileños en los países andinos.
Anteriormente, dependíamos de los productos holandeses y europeos. Al acercar nuestra logística, nuestro objetivo es garantizar precios más atractivos, entregas más rápidas y una gestión más ágil. Nuestra intención es aplicar la astucia adquirida en Brasil, también en los países andinos.
¿Cuál es la expectativa de expansión del mercado?
En los próximos tres años, nuestro objetivo es alcanzar aproximadamente el 10% de la facturación de Koppert Brasil en los países andinos. Con la introducción de nuevos productos, queremos superar ese objetivo.
¿Qué ha sentido hasta ahora viviendo en Chile?
Brasil es líder mundial en el uso de productos biológicos, con una tasa de adopción de alrededor de 30%. En los países andinos, esta tasa es significativamente menor, oscilando entre el 7 y el 8 %. Sin embargo, hemos observado una creciente aceptación de los productos biológicos en esta región, indicando una tendencia positiva para su futura adopción.
¿Qué desafíos ha visto?
En la actualidad, nos enfrentamos al reto de tratar con productores que aún mantienen el escepticismo con relación a los biológicos.
De los cuatro países, ¿alguno se ha destacado?
La fruticultura en Chile es un área destacada. Las grandes empresas del sector, que son importantes agroexportadores, han mostrado una excelente acogida a los productos
biológicos. Observo una mayor entrada de estos productos en el mercado chileno.
¿Los productores tienen una idea real sobre el rápido crecimiento de los biológicos en Brasil?
¿O están asombrados?
La mayoría de las personas no tienen ciencia del rápido crecimiento que está experimentando Brasil en este campo. Esas personas reconocen que Brasil está bien establecido en el área de biológicos, pero desconocen las cifras que hay detrás de este progreso. Cuando presento estos datos, las personas se quedan impresionadas con el potencial de crecimiento. De hecho, todos comparten el deseo de ver este avance, pues el mercado ya muestra una preferencia por productos sostenibles. Anteriormente, la producción de vino en Chile no era frecuentemente asociada con sustentabilidad, pero hoy en día esta mentalidad es cada vez más común.
Me imagino que otros cultivos también tengan esta tendencia, ¿verdad?
Claro que sí. Los grandes agroexportadores siguen la tendencia de los biológicos, buscando ampliar y comercializar una producción más sostenible para sus clientes. El movimiento hacia los productos biológicos es irreversible.
¿Y cómo ha sido su día a día, su trabajo?
Actualmente vivo en Santiago, en Chile. En los primeros meses, concentré mis esfuerzos en Chile, aunque estuve atento a todos los países de la región. Ahora, estoy dirigiendo mi atención también al Perú, profundizando paulatinamente mi estrategia en cada país.
¿Cómo ha sido la discusión sobre el Sistema Integrado Koppert en Chile? Inicialmente, ellos consideran que se trata de una gestión biológica completa, pero en realidad no lo es. Actualmente,
adoptamos la gestión integrada, que combina abordajes químicos y biológicos, y esto ayuda a clarificar errores. Al explicar a una empresa que, hasta entonces, no estaba familiarizado con los productos biológicos, el potencial para reducir el uso de productos químicos, junto con los beneficios para el cultivo, como la reducción de enfermedades y plagas, la aceptación de los biológicos aumenta.
¿Las empresas más tradicionales han dirigido sus esfuerzos sobre el tema de los bioinsumos en los países andinos?
Estas empresas han dirigido sus esfuerzos en esta dirección, aunque no con la misma intensidad observada en Brasil. Mientras que Brasil está más avanzado en este sentido, los demás países avanzan más lentamente, pero siguen una trayectoria similar.
¿Cómo usted se ha sentido en la agricultura? Cuéntanos un poco sobre ese mercado.
El año pasado hubo una situación desfavorable para la producción frutícola en Chile debido al exceso de lluvias en los países andinos. Esto se tradujo en una caída de la productividad y en los precios. Actualmente, con la transición de El Niño a La Niña, se espera un año con menos precipitaciones, lo que indica una expectativa de excelente producción y precios estables. Esta perspectiva también se aplica en Perú.
¿Cuál es el mensaje que está frente a esta expansión, la oportunidad que Brasil viene buscando con relación a los países andinos?
Creo que Koppert podrá compartir su sabiduría y contribuir a la producción de una agricultura más sostenible en todos los países andinos. Con eso, tendremos a disposición productos de mejor calidad, que causarán menos impacto al medio ambiente. Es sumamente gratificante ser parte de este proceso y ser testigo de su culminación.
5 BioJournal | Año 11 | Edición 01 | TRIMESTRAL 2024
PORTADA
Koppert Brasil asume la operación de la empresa en los países andinos y comienza a gestionar Koppert Sudamérica
En una jugada estratégica para fortalecer su presencia en América del Sur, Koppert Brasil tomó el control de las unidades de la compañía en los países andinos, incluyendo Chile, Colombia, Ecuador y Perú. Esta expansión de negocios marca un nuevo capítulo en la historia de Koppert, consolidando su posición como líder en soluciones de control biológico en la región.
La sucursal brasileña, ya encargada de las operaciones en Argentina, Uruguay y Paraguay, ahora asume el comando de Koppert Sudamérica. Bajo la dirección del director comercial, Gustavo Herrmann, y del director industrial, Danilo Pedrazzoli, Koppert Brasil está preparada para liderar e impulsar el crecimiento de la empresa en toda la región.
Anteriormente, la administración de las unidades en los países andinos estaba bajo la supervisión de las directorias de Holanda y de los Estados Unidos. Sin embargo, la centralización de la gestión

de Koppert Brasil tiene como objetivo facilitar la implementación del control biológico y aumentar la presencia de la empresa en América del Sur. “La estrategia consiste en centralizar la gestión para, con la proximidad física, acelerar la adopción del control biológico y ampliar la presencia de la empresa en estos países”, explica André Martins, gerente general de Koppert Andina.
Con la integración de los bioinsumos producidos en Brasil al portafolio comercializado en América del Sur, Koppert espera lograr un aumento del 10% en su facturación local. Actualmente, el equipo que opera en los países andinos está conformado por cerca de 30 colaboradores, pero se espera que ese número aumente significativamente a partir de 2026.
El mercado agrícola de los países andinos tiene sus particularidades, con un enfoque en la producción de frutas, plantas ornamentales, hortalizas en cultivo protegido, café y caña de azúcar.

Aun así, Koppert continuará ofreciendo una amplia gama de productos, incluyendo alrededor de 30 bioinsumos importados de Holanda. Además, tres productos biológicos brasileños -Trichodermil (Trichoderma harzianum 1306), Boveril Evo (Beauveria bassiana PL63) y Octane (Isaria fumosorosea 1296) - entrarán en el mercado andino, demostrando el compromiso de la empresa en proveer soluciones innovadoras y sostenibles para los agricultores de la región.
Esta expansión de negocios marca un nuevo capítulo en la historia de Koppert, consolidando su posición como líder en soluciones de control biológico en la región.
6
Danilo Pedrazoli, Director Industrial, junto a Gustavo Herrmann, Director Comercial de Koppert Brasil

7 BioJournal | Año 11 | Edición 01 | TRIMESTRAL 2024
Koppert recibe una inversión estratégica de HAL Investments para ampliar su operación global
Koppert, empresa importante en el suministro de soluciones sostenibles para horticultura y agricultura, anunció recientemente una inversión estratégica por parte de HAL Investments, un importe de 140 millones de euros en capital social preferencial. Esta inyección de capital tiene como objetivo impulsar el crecimiento de la empresa y fortalecer su posición como líder en el sector de soluciones biológicas agrícolas.
Con una red internacional de sucursales y varias instalaciones de producción en todo el mundo, Koppert tiene como objetivo promover prácticas agrícolas más saludables, seguras y productivas. Por medio de un sistema integrado de conocimiento especializado y soluciones naturales, la empresa busca mejorar la salud y la producción de los cultivos.
La inversión de HAL Investments se dirigirá principalmente a la expansión de las instalaciones de producción y del capital de giro de Koppert para apoyar el crecimiento global de la empresa.

Además, esta sociedad estratégica abre puertas para inversiones futuras y refuerza la posición de Koppert en el mercado de licencias, fusiones y adquisiciones.
René Koppert, CEO de Koppert, expresó su satisfacción con la sociedad: “Nos complace dar la bienvenida a HAL Investments como socio estratégico e inversionista a largo plazo. Juntos, Koppert y HAL comparten la visión de impulsar cambios positivos. Esta colaboración acelerará nuestras iniciativas de investigación y desarrollo, impulsando la creación de soluciones de vanguardia para la agricultura biológica y sostenible.”
Con el apoyo de HAL Investments, Koppert espera acelerar su crecimiento y causar un impacto aún más significativo en la agricultura global, aportando soluciones innovadoras y sostenibles para los retos del sector.
Esta colaboración acelerará nuestras iniciativas de investigación y desarrollo, impulsando la creación de soluciones de vanguardia para la agricultura biológica y sostenible.

René Koppert CEO de Koppert
INVERSIÓN
8
Sede de Koppert en Holanda
RECONOCIMIENTO
Premio de Innovación Tecnológica: Koppert es Reconocida en Fruit Logística
Koppert recibió un reconocimiento internacional por su excelencia en innovación durante la Fruit Logística, el evento mundial más importante para la industria de productos frescos y frutas. La empresa fue galardonada con el Premio de Innovación Tecnológica por su avanzado sistema de liberación del producto Mirical (Macrolophus pygmaeus), desarrollado por la holandesa Koppert.
El nuevo sistema no solo mejora la precisión de la aplicación del insecto depredador, sino que también demuestra un firme compromiso con la sostenibilidad, reduciendo el uso
de plástico en un 99%. Este logro representa un hito importante en el sector agrícola, destacando el liderazgo de Koppert en tecnología e innovación.
Desde su fundación en 1967, Koppert ha sido pionera en Investigación y Desarrollo, dedicándose incansablemente a la creación de soluciones que hace que la agricultura sea más sostenible, rentable y productiva. El reconocimiento de este premio refuerza el compromiso continuo de la empresa, en promover las prácticas agrícolas ambientalmente responsables y eficientes.


Koppert reitera su lema: “¡Biológico es Koppert!” y continúa liderando el camino para un futuro agrícola más sostenible y próspero. Con un historial comprobado de innovación y excelencia, la compañía está comprometida con la impulsión de la industria agrícola rumbo a nuevas fronteras de suceso y sostenibilidad.
Este logro representa un hito importante en el sector agrícola, destacando el liderazgo de Koppert en tecnología y innovación.
9 BioJournal | Año 11 | Edición 01 | TRIMESTRAL 2024
Representantes de Koppert reciben el premio “Innovación Tecnológica” durante el evento
DESAFÍO X
SOLUCIÓN
Productos biológicos: la clave para un manejo eficaz de la cigarrita del maíz
La cigarrita del maíz (Dalbulus maidis) es una plaga de gran desafío para los productores, causando pérdidas significativas de productividad e impactando directamente en el retorno económico de cultivos. Propagada desde el sur al norte del país, esta plaga es un problema crónico que afecta a casi todas las regiones donde se cultiva el maíz, incluso en Paraguay.
El control de la cigarrita del maíz requiere estrategias eficientes y sostenibles. Es en este contexto. que un manejo integrado con productos biológicos, como el hongo entomopatógeno Octane (Isaria fumosorosea 1296) de Koppert, desempeña un papel clave.
Además de contribuir para una gestión más equilibrada y sostenible, Octane rompe la resistencia de la plaga, lo que ayuda a mantener a su población bajo control. “Hoy Koppert tiene una herramienta que viene revolucionando

muy bien el mercado, para poder contribuir con el productor para el manejo de esta plaga”, afirma Marcelino Brito, Gerente de Desarrollo de Mercado de Koppert Brasil, refiriéndose al bioinsecticida en el combate a la cigarrita del maíz. Esta estrategia, combinada con otras medidas, como un tratamiento adecuado de las semillas, la elección de híbridos tolerantes y la programación de una ventana de plantación, contribuye a minimizar los daños causados por la plaga.
Cabe mencionar que Octane, (Isaria fumosorosea 1296) aplicado de acuerdo con la presencia de la plaga, ofrece una solución eficaz no solo para el control de la cigarrita del maíz, sino también para otras plagas como trips, araña roja (Tetranychus urticae), cochinilla de roseta, Psílido de concha y Psílido, siendo versátil en varios cultivos donde se encuentran estas plagas.

Cada costal de gestión invertida da como resultado un retorno económico de 5 a 10 costales de liquidez (...)
 Maurício Pasini Consultor e Investigador
Maurício Pasini Consultor e Investigador
10
El hongo entomopatógeno Octane (Isaria fumosorosea 1296) de Koppert


De acuerdo con Mauricio Pasini, Consultor e Investigador, con la incorporación de una gestión integrada con Octane, los productores pueden ver una mejoría significativa en la productividad y en la rentabilidad de sus cultivos. “Cada costal de gestión invertida da como resultado un retorno económico de 5 a 10 costales de liquidez, y esto se relaciona, principalmente, al mantenimiento de la población reducida de la plaga durante el desarrollo del cultivo”, añade Pasini.
Ante este panorama, es evidente que los biológicos son una herramienta esencial para el manejo integrado de plagas, ofreciendo una alternativa eficaz y sostenible para los desafíos enfrentados por los productores en el control de la cigarrita del maíz.

¡Visite el canal de YouTube de Koppert y eche un vistazo a todas las soluciones y contenidos enfocados en el manejo del maíz y otros cultivos!
Imágenes
11 BioJournal | Año 11 | Edición 01 | TRIMESTRAL 2024
ilustrativas. Todos los derechos reservados.
NUEVA TEMPORADA
com Renata Maron
Koppert
Biotalks:
Recapitulando
la primera temporada y preparándose para la próxima

La presentadora Renata Maron en el set de la segunda temporada de Koppert Biotalks
La jornada de Koppert Biotalks ha sido un viaje marcante por el mundo de la agricultura sostenible, destacando prácticas innovadoras, desafíos y soluciones para un futuro agrícola más prometedor. Contando con la presencia de diversos invitados y temas relevantes, la primera temporada aportó valiosas ideas y perspectivas inspiradoras para los productores y entusiastas del sector. ¿Qué tal si hacemos una rápida retrospectiva?
El episodio inaugural de la primera temporada de Koppert Biotalks, lanzado el 5 de enero, contó con la presencia de Eduardo Leão de Sousa, CEO de CropLife Brasil.
Las prácticas agrícolas sostenibles y el impacto de las biotecnologías en la agricultura fueron discutidos. El 10 de enero, Marcelino Borges de Brito
y Glauber Renato Stürmer aportaron informaciones sobre los desafíos y oportunidades del control biológico en la agricultura brasileña. El tercer episodio contó con la presencia de Renata Potenza, de Imaflora, quien compartió reflexiones sobre el desarrollo de sistemas productivos sostenibles y la reducción de las emisiones de carbono. Rodrigo Lima, de Agroicone, participó del Biotalks el día 17 de enero y destacó la visión de futuro de la agricultura brasileña y la implementación de acciones sostenibles. Ya, Marcelino Borges de Brito y Mariana Ferreira Rabelo Fernandes, el 29 de enero, exploraron los beneficios del bioactivador para el sustento de los cultivos. Terminando la primera temporada con broche de oro el 21 de febrero, el invitado fue el Dr. José Roberto Postali Parra, de Sparcbio, que abordó el papel de la investigación en la ampliación del acceso al control biológico.
Ahora, ¡le invitamos a seguir la próxima temporada de Koppert Biotalks que ya empezó! El primer episodio ya está disponible, y esta vez, el enfoque fue en la plantación de caña de azúcar de alta calidad, con los Doctores Marcos Landell y Leonardo Pereira.
Nuevos invitados, temas relevantes y discusiones estimulantes le esperan. Júntese a nosotros mientras continuamos nuestra búsqueda por un futuro agrícola más sostenible y próspero.
Escanee el código QR y vea la nueva temporada de Koppert BioTalks.

12
Día Internacional de la Mujer: Reconociendo el Papel Fundamental de las Mujeres en el Agronegocio
En el Día Internacional de la Mujer, Koppert promovió una serie de acciones para homenajear y reconocer la importancia de las mujeres en el sector agrícola. En una iniciativa especial, algunas mujeres de las unidades de Koppert América del Sur fueron seleccionadas para representar a toda esta clase de profesionales del agro.
A través de los ojos de estas mujeres y de tantas otras que contribuyen diariamente para que la agricultura sea más sostenible, Koppert celebra el talento, la dedicación y el trabajo duro de estas profesionales. El Día Internacional de la Mujer es una oportunidad no solo para reconocer los logros de las mujeres, sino también para reflexionar sobre los desafíos a los que aún se enfrentan en el campo.
En este contexto, es importante destacar la fuerza de la mujer que se dedica a la agricultura. Con su importante presencia y su determinación incansable, las mujeres desempeñan un papel crucial

simbólico de aprecio y reconocimiento por la contribución de las mujeres al desarrollo del agronegocio. Esta acción no solo celebró el Día Internacional de la Mujer, sino que también, destacó la importancia de fomentar un ambiente de trabajo inclusivo y variado.
Koppert reafirma su compromiso en seguir apoyando y valorando a las mujeres en todas las esferas del agronegocio, reconociendo su invalorable contribución para la agricultura sostenible y productiva.

HOMENAJE
13 BioJournal | Año 11 | Edición 01 | TRIMESTRAL 2024
DESAFÍO X
SOLUCIÓN
Metarril (Metarhizium anisopliae E9): Control eficiente de la cigarrita de la raíz
El Metarril (Metarhizium anisopliae E9) se ha destacado como bioinsecticida microbiológico altamente eficaz en el control de la cigarrita de la raíz (Mahanarva fimbriolata), una plaga que afecta a varios cultivos. Con una formulación innovadora y eficiente, el Metarril ofrece una dosis adecuada para la lucha contra esta plaga, proporcionando una solución segura y sostenible para los agricultores.
Este bioinsecticida actúa en diferentes etapas del ciclo de vida de la cigarrita de la raíz, garantizando una protección integral y duradera de las plantaciones. Además, el Metarril se puede utilizar en cualquier cultivo en el que la cigarrita de la raíz esté presente, ofreciendo una solución versátil que se puede adaptar a las necesidades de los productores.

Entre los principales beneficios del producto, se destacan:
1) Ideal para el Manejo Integrado de Plagas (MIP)
El Metarril es una herramienta fundamental para el Manejo Integrado de Plagas, permitiendo el control efectivo de la cigarrita de la raíz preservando el equilibrio del ecosistema agrícola.

2) Adecuado para Manejo de Resistencia de InsectosPlagas a Insecticidas Químicos
El uso continuado de insecticidas químicos puede conducir al desarrollo de resistencia por parte de las plagas. El Metarril ofrece una alternativa eficaz para el manejo de esta resistencia, ayudando a los agricultores a diversificar sus estrategias del control de plagas.
3) Preserva a los Enemigos Naturales de las Plagas
Al contrario de los insecticidas químicos, que a menudo tienen efectos colaterales perjudiciales para los enemigos naturales de las plagas, el Metarril preserva la biodiversidad del medio agrario, contribuyendo para un ecosistema más equilibrado y saludable.
14


Con el Metarril, los agricultores pueden confiar en una solución eficiente y sostenible para el control de la cigarrita de la raíz, garantizando así, la salud y la productividad de sus plantaciones.
Peste (Mahanarva fimbriolata) colonizada por Metarril®, en cultivos de caña de azúcar en el interior de São Paulo. Foto: Colección Koppert Brasil.
15 BioJournal | Año 11 | Edición 01 | TRIMESTRAL 2024
Imágenes ilustrativas. Todos los derechos reservados.
SOSTENIBILIDAD
Sociedad estratégica para una agricultura sostenible firmada entre Koppert e IBRAHORT
Koppert y el Instituto Brasileño de Horticultura (IBRAHORT) anunciaron una sociedad estratégica con el objetivo de promover prácticas sostenibles en la agricultura.
Esta unión tiene como objetivo profundizar el conocimiento del sector horticultura y alinear estrategias para contribuir de manera más efectiva con los agricultores, especialmente en el uso consciente de los bioinsumos.
De acuerdo con Fernando Gilioli, Gerente Regional de Marketing de Koppert, “a través de esta iniciativa con IBRAHORT, ponemos a Koppert a la vanguardia con los grandes productores de la cadena horticultura en Brasil”.
Gilioli también señala que esta alianza proporcionará a Koppert acceso directo a la cadena de la horticultura, ayudando al sector a comprender y utilizar mejor los productos biológicos, teniendo en cuenta las crecientes demandas de los consumidores por prácticas más sostenibles.


La primera acción conjunta ya está programada para el 19 de abril, durante la 2ª Reunión Nacional IBRAHORT, en Holambra (SP). En la ocasión, Koppert presentará la conferencia “Bioinsumos, el movimiento innovador en la protección de las plantas”, abordando la importancia y los beneficios de los bioinsumos en la horticultura.
Para formalizar la alianza, Manoel Oliveira, director de IBRAHORT, visitó la sede de la Koppert en Piracicaba (SP), donde se discutieron los compromisos mutuos y acciones conjuntas previstas para el año.
Esta sociedad refuerza el compromiso de Koppert y de IBRAHORT con una agricultura más sostenible, eficiente y productiva, proporcionando beneficios tanto para los productores como para el medio ambiente.
16
Felipe Itihara, Gerente de Innovaciones, Alexandre Mistrelo, Coordinador de Inteligencia de Mercado y Fernando Gilioli, Gerente Regional de Marketing dieron la bienvenida a Manoel Oliveira, Director de IBRAHORT
Eche un vistazo a las visitas que hemos recibido en el último trimestre RECEPTIVO KOPPERT

Nuestro receptivo recibió socios, clientes y especialistas, que visitaron las plantas de producción de Koppert en Piracicaba (SP) y Charqueada (SP). El proyecto tiene como objetivo presentar la estructura y la calidad de Koppert a los visitantes, que tienen la oportunidad de conocer los laboratorios de Investigación y Desarrollo y las fábricas de micro, macrobiológicos y de formulaciones.
Agradecemos la presencia de los representantes de Coplacana y Usina da Pedra (30/01). Suprema Agro, Soma Agropecuaria (21/02), Gobierno de Quebec, Agroazul (21/02), Grupo Viterra (29/02), Valor Agrícola, Fazendas HP, FC Consultoría, Apoio Agrícola y Fazenda Invernadinha (05/03).




30/Ene 29/Feb 05/Mar 21/Feb 21/Feb 17 BioJournal | Año 11 | Edición 01 | TRIMESTRAL 2024
FERIAS Y EVENTOS
La presencia de Koppert se destaca en los eventos de las principales regiones productoras de Brasil
10 al 12 de enero Dinetec (Canarana/MT)
Koppert está presente en los mayores eventos, ferias y congresos del agronegocio brasileño. Junto a los socios, consultores e investigadores, aprovecha las ventajas del control biológico para todas las regiones de Brasil. Compruébelo a continuación:


11 y 12 de enero
Open Sky Soja (Sorriso/MT)

18
17 y 18 de enero
Safratec (Londrina/PR)

23 al 25 de enero
Dia del Campo Lar (Medianera/PR)


31 de enero al 02 de febrero
Agrotec Integrada (Assaí/PR)

19 BioJournal | Año 11 | Edición 01 | TRIMESTRAL 2024
FERIAS Y EVENTOS

30 de enero al 02 de febrero
Belasafra (Cambé/PR)

17 de febrero
Dia del Campo PA Consultoria (Tangará da Serra/MT)


19 al 23 de febrero
Congresso Brasileiro de Micologia (Belo Horizonte/MG)
20
21 y 22 de febrero
Show Tecnológico de Verão
(Ponta Grossa/PR)

27 al 29 de febrero
Show Tecnológico
Copercampos
(Campos Novos/SC)


06 y 07 de marzo
Datagro - abertura de safra
(Ribeirão Preto/SP)
26 de febrero al 01 de marzo
Coplacampo
(Piracicaba/SP)

21 BioJournal | Año 11 | Edición 01 | TRIMESTRAL 2024
FERIAS Y EVENTOS
07 al 09 de marzo
Koppert Experience
(Rio Quente/GO)





22
07 al 09 de marzo
AgroRosário (Correntina/BA)

18 al 22 de marzo
Showsafra (Lucas do Rio Verde/MT)



12 al 15 de marzo
FarmShow (Primavera do Leste/MT)
14 y 15 de marzo
RAV Adubos Real (Itapeva/MG)

23 BioJournal | Año 11 | Edición 01 | TRIMESTRAL 2024
PARAGUAY
Koppert lanza
Trichodermil 1306 (Trichoderma harzianum) con nueva formulación (FS) para el tratamiento de semillas en Paraguay

Líder mundial en soluciones biológicas para la agricultura, Koppert participó en el evento La Noche del Campo de Somax Agro, realizado el 13 de marzo en San Alberto, Paraguay.
El evento reunió a reconocidos conferencistas y entusiastas del sector agrícola para una jornada de innovaciones en el campo, brindando una excelente oportunidad para destacar los beneficios de los bioinsumos.
Durante el evento, la multinacional holandesa reveló al público y a sus socios el lanzamiento de Trichodermil 1306 (Trichoderma harzianum 1306), con la innovadora formulación Suspensión Concentrada para Tratamiento de Semillas. El producto está registrado en el SENAVE con el número 7539.
Trichodermil 1306 ya es una marca reconocida en Paraguay, sin embargo, ha sido mejorado con una nueva versión especialmente desarrollada para el Tratamiento de Semillas (TS) y el Tratamiento de Semillas Industriales (TSI), incorporando la tecnología innovadora en su formulación FS. Esta formulación proporciona una doble protección a las semillas frente a los hongos y nematoides fitopatógenos del suelo, con registro para: Fusarium solani. Rhizotonia solani y Pratyenchus zeae.
Entre los beneficios operacionales de Trichodermil 1306 se encuentran su formulación FS, que permite una dosis baja y un secado rápido, además de ser altamente compatible con otros tratamientos y permitir el almacenamiento de las semillas tratadas hasta 20 días para el Tratamiento
de Semillas y hasta 60 días para el Tratamiento de Semillas Industriales antes de la cosecha.
Para la siembra, el Trichodermil 1306 ofrece una serie de ventajas, incluyendo una mayor protección de las raíces contra nematodos y hongos fitopatógenos, una mejora en la salud de los cultivos, un mayor desarrollo de las raíces, una mayor productividad de las plantas y, en consecuencia, mayor rentabilidad.
Koppert reafirma su compromiso con la agricultura sostenible y con la salud de las plantas, proporcionando soluciones innovadoras que contribuyan al éxito y a la rentabilidad de los agricultores en Paraguay y en todo el mundo.
24
ARGENTINA














 Maurício Pasini Consultor e Investigador
Maurício Pasini Consultor e Investigador